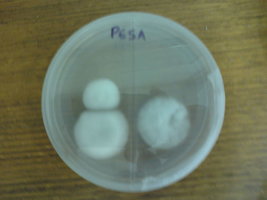

Por favor, leia com atenção as Regras e o Termo de Responsabilidade do Fórum. Ambos lhe ajudarão a entender o que esperamos em termos de conduta no Fórum e também o posicionamento legal do mesmo.
InducedComa Me parece que a turfa vai disponibilizando os nutrientes mais lentamente para o micélio, então pensei em fazer uma mistura da turfa com uma outra que disponibilize em tempo mais curto... Alguém tem alguma dica?
InducedComa Me parece que a turfa vai disponibilizando os nutrientes mais lentamente para o micélio, então pensei em fazer uma mistura da turfa com uma outra que disponibilize em tempo mais curto... Alguém tem alguma dica?